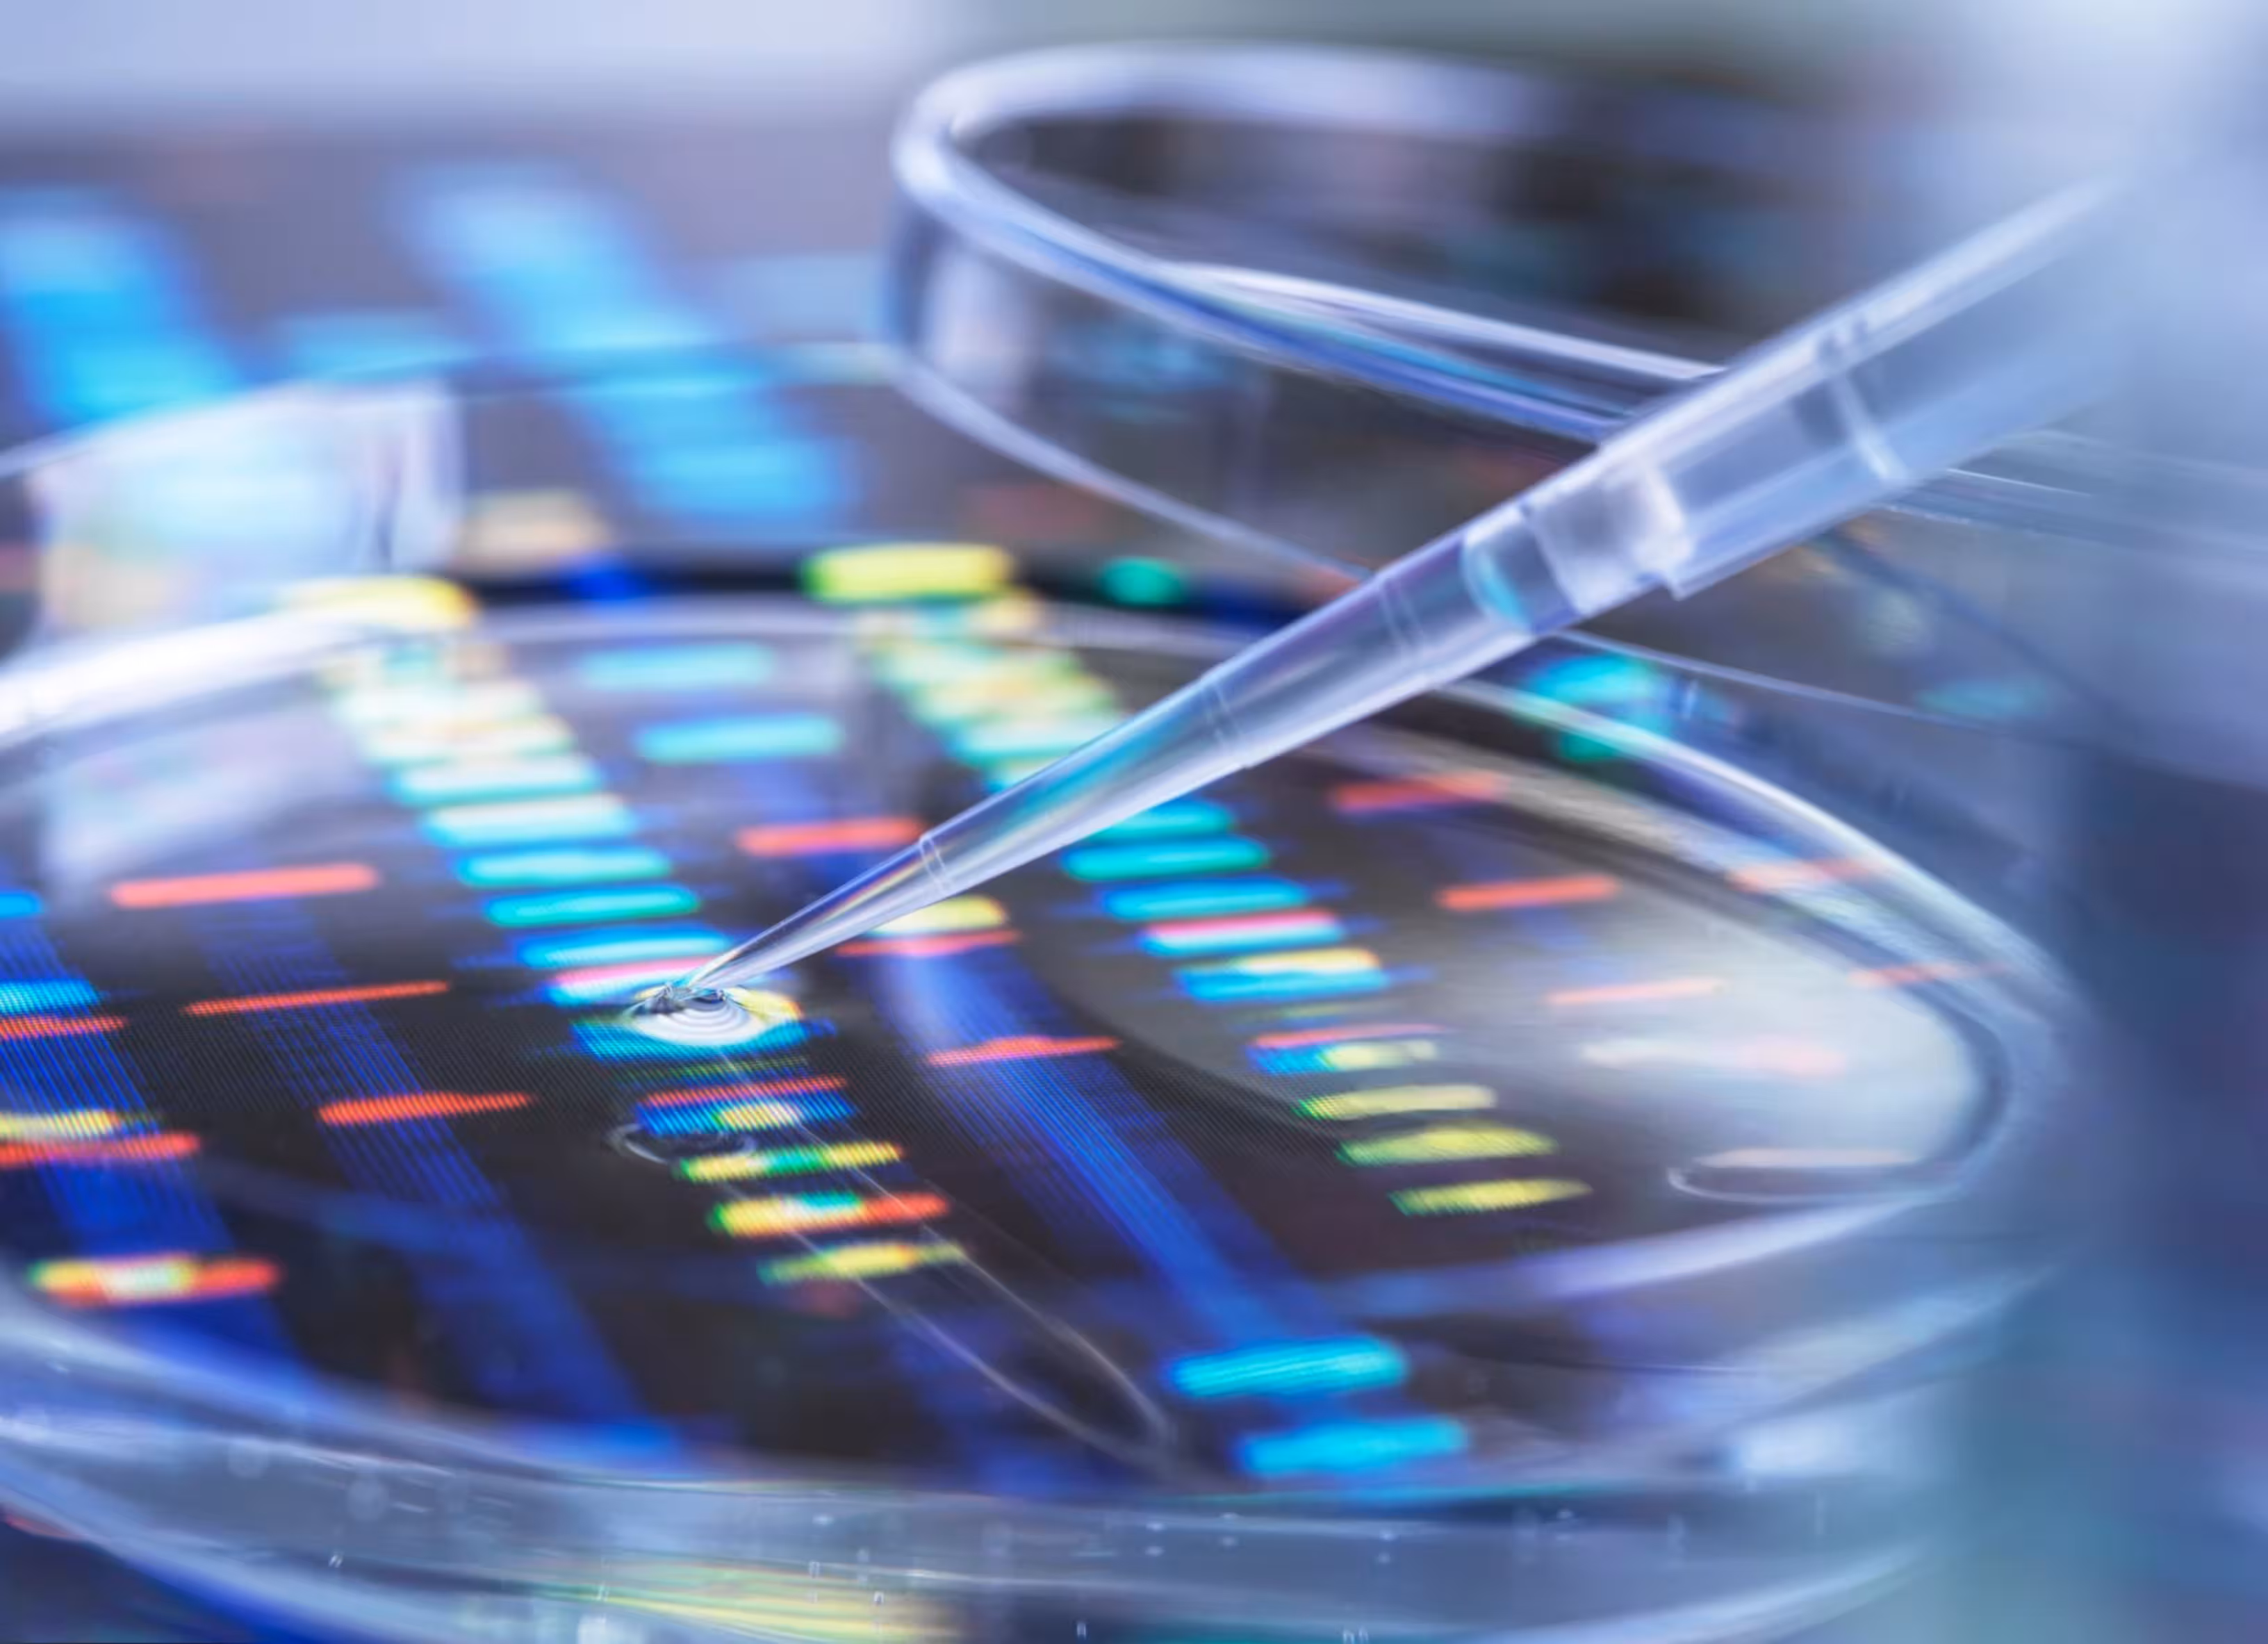

Genetic Screening
Gain insight into potential genetic factors that may influence your fertility or pregnancy, helping guide confident decisions.
About genetic screening
Genetic screening provides important information for individuals and couples planning a pregnancy. Current guidelines recommend that everyone considering pregnancy think about carrier screening, as it can identify whether they carry genetic variants that could be passed on to a child. Screening can be done in two ways: a basic three-gene panel, or expanded carrier screening, which assesses more than 400 conditions.

Why carrier screening matters
Carrier screening is valuable because many people who carry a genetic condition have no symptoms and no family history. When both partners carry a variant in the same gene, there is a higher chance of having a child affected by that condition. Identifying this early allows for a range of reproductive options to reduce that risk, including the use of IVF with pre-implantation genetic testing of embryos or specialised early pregnancy testing.
Reducing risk and planning with confidence
The aim of genetic screening is to provide clarity, risk reduction and reassurance. By understanding potential risks before conception or early in fertility treatment, individuals and couples can make informed decisions and take steps that support the best chance of having a healthy child.
You can find out more about carrier screening including ordering the test here .
Frequently asked questions

What is carrier screening and who should consider it?
Carrier screening checks whether you carry certain genetic variants that could be passed on to a child; it is recommended that all individuals or couples planning a pregnancy consider this testing.
What is the difference between basic carrier screening and expanded screening?
Basic screening typically looks at a small number of common conditions, while expanded screening assesses hundreds of conditions and provides broader information about possible genetic risks.
How can carrier screening reduce the risk of having a child with a genetic condition?
If both partners carry a variant in the same gene, options such as IVF with pre-implantation genetic testing, use of donor eggs or sperm, or specific pregnancy planning can reduce the chance of an affected child.
Is genetic screening mandatory before treatment?
No. It is an option, not a requirement, but is strongly recommended so that decisions about treatment and family planning are made with as much information as possible.






Your dream of starting a family begins with a conversation
Reach out to Dr Thalluri and his team for compassionate, evidence based care designed around your hopes and needs.











